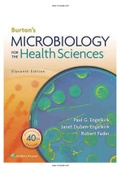

Engelkirk Study guides, Class notes & Summaries
Looking for the best study guides, study notes and summaries about Engelkirk? On this page you'll find 61 study documents about Engelkirk.
All 61 results
Sort by

-
Test Bank For Burton's Microbiology for the Health Sciences, Enhanced Edition 11th Edition By Paul G. Engelkirk; Janet Duben-Engelkirk; Robert C. Fader 9781284209952 Chapter 1-21 Complete Guide .
- Exam (elaborations) • 368 pages • 2023
-
- $26.36
- 5x sold
- + learn more
Test Bank For Burton's Microbiology for the Health Sciences, Enhanced Edition 11th Edition By Paul G. Engelkirk; Janet Duben-Engelkirk; Robert C. Fader 9952, 4 . 5372, 2 1 Microbiology—The Science 2 Viewing the Microbial World 3 Cell Structure and Taxonomy 4 Acellular and Prokaryotic Microbes 5 Eukaryotic Microbes 6 The Biochemical Basis of Life 7 Microbial Physiology and Genetics 8 Controlling Microbial Growth In Vitro 9 Inhibiting the Growth of Pathogens In Vivo us...
A Complete Test Bank For Burtons Microbiology for the Health Sciences, 9th Edition Paul G Engelkirk, Janet

-
Test Bank For Burton's Microbiology for the Health Sciences, Enhanced Edition 11th Edition By Paul G. Engelkirk; Janet Duben-Engelkirk; Robert C. Fader 9781284209952 Chapter 1-21 Complete Guide .
- Exam (elaborations) • 368 pages • 2023
-
- $26.38
- 1x sold
- + learn more
Test Bank For Burton's Microbiology for the Health Sciences, Enhanced Edition 11th Edition By Paul G. Engelkirk; Janet Duben-Engelkirk; Robert C. Fader 9952, 4 . 5372, 2 1 Microbiology—The Science 2 Viewing the Microbial World 3 Cell Structure and Taxonomy 4 Acellular and Prokaryotic Microbes 5 Eukaryotic Microbes 6 The Biochemical Basis of Life 7 Microbial Physiology and Genetics 8 Controlling Microbial Growth In Vitro 9 Inhibiting the Growth of Pathogens In Vivo u...
Burton’s Microbiology for the Health Sciences 11th Edition Engelkirk Test Bank Instant delivery

-
Burton’s Microbiology for the Health Sciences 11th Edition Engelkirk Test Bank
- Exam (elaborations) • 366 pages • 2022
-
- $25.89
- 2x sold
- + learn more
Burton’s Microbiology for the Health Sciences 11th Edition Engelkirk Test Bank. To clarify, this is a test bank, not a textbook. You have immediate access to download your test bank. No delays, loading is fast and instant immediately after ordering! You will receive a full bank of tests; in other words, all chapters will be there. Test banks are presented in PDF format; therefore, no special software is required to open them.

-
Burton’s Microbiology for the Health Sciences 11th Edition Engelkirk Test Bank
- Exam (elaborations) • 366 pages • 2022
-
- $28.44
- 1x sold
- + learn more
Burton’s Microbiology for the Health Sciences 11th Edition Engelkirk Test Bank. To clarify, this is a test bank, not a textbook. You have immediate access to download your test bank. No delays, loading is fast and instant immediately after ordering! You will receive a full bank of tests; in other words, all chapters will be there. Test banks are presented in PDF format; therefore, no special software is required to open them.
Burton’s Microbiology for the Health Sciences 11th Edition Engelkirk Test Bank. Instant delivery .
Test Bank For Burton's Microbiology For the Health Sciences 9th edition by Paul G. Engelkirk Complete Test Bank

-
Test Bank For Burton's Microbiology for the Health Sciences, Enhanced Edition 11th Edition By Paul G. Engelkirk; Janet Duben-Engelkirk; Robert C. Fader 9781284209952 Chapter 1-21 Complete Guide .
- Exam (elaborations) • 368 pages • 2023
-
- $26.38
- + learn more
Test Bank For Burton's Microbiology for the Health Sciences, Enhanced Edition 11th Edition By Paul G. Engelkirk; Janet Duben-Engelkirk; Robert C. Fader 9952, 4 . 5372, 2 1 Microbiology—The Science 2 Viewing the Microbial World 3 Cell Structure and Taxonomy 4 Acellular and Prokaryotic Microbes 5 Eukaryotic Microbes 6 The Biochemical Basis of Life 7 Microbial Physiology and Genetics 8 Controlling Microbial Growth In Vitro 9 Inhibiting the Growth of Pathogens In Vivo u...

-
Burton's Microbiology For the Health Sciences 9th edition by Paul G. Engelkirk - Test Bank
- Exam (elaborations) • 177 pages • 2023
- Available in package deal
-
- $21.24
- + learn more
A) B) C) D) Which one of the following characteristics do 1. animals, fungi, and protozoa have in common? They obtain their carbon from carbon dioxide. They obtain their carbon from inorganic compounds. They obtain their energy and carbon atoms from chemicals. They obtain their energy from light. 2. A) B) C) D) 3. A) B) C) D) 4. A) B) C) D) 5. A) B) C) D) Most ATP molecules are produced during which phase of aerobic respiration? electron transport c...

Study stress? For sellers on Stuvia, these are actually golden times. KA-CHING! Earn from your study resources too and start uploading now. Discover all about earning on Stuvia